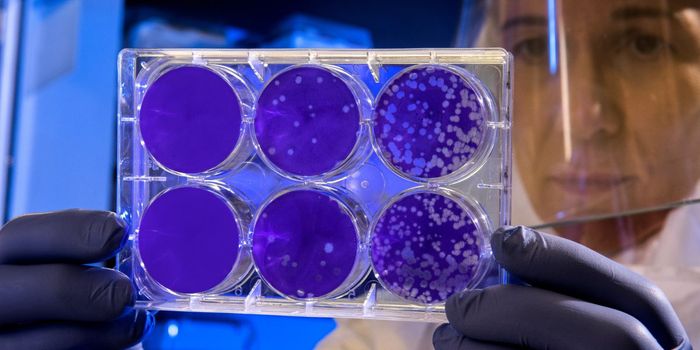
China Approves Trials for Favipiravir to Treat Coronavirus

Parallel Computing
Parallel computing is a high-performance type of computation where many calculations are performed at the same time. Parallel computing is used to solve large problems by dividing them into many small problems which can be solved simultaneously. Smartphones and laptops are examples of devices which use parallel computing.
-
DEC 07, 2023Cell & Molecular BiologyBacteria are everywhere, and so are the sticky, slimy communities they can form, called biofilms. These tough bacterial ...Written By: Carmen LeitchJUN 25, 2022Genetics & GenomicsCephalopods, including octopuses, have exceptionally large and complex nervous systems; the octopod brain is thought to ...Written By: Carmen LeitchJUN 04, 2022ImmunologyOur immune system is a crucial, and has to be ready to respond to a variety of external threats that we are constantly e ...Written By: Carmen LeitchAUG 12, 2021Clinical & Molecular DXResearchers have developed a new technology for the non-invasive diagnosis of thyroid cancer that combines photoacoustic ...Written By: Tara FernandesAUG 05, 2021TechnologyToday, the Ethernet connection has emerged as one of the most popular ways to make the most out of an internet connectio ...Sponsored By: Kamil Web Solutions LuJUN 15, 2021Genetics & GenomicsWe live in an age of information and data, and more is being generated every day. It's estimated that there are about te ...Written By: Carmen LeitchMAR 30, 2021Cell & Molecular BiologyWhen cells were given a tiny 'tightrope' they 'walked' it, and researchers have discovered a new kind of cellular moveme ...Written By: Carmen LeitchMAR 12, 2021MicrobiologyMany bacteria that infect intestinal cells make and release bacterial proteins into their host in order to hijack cell f ...Written By: Carmen LeitchFEB 23, 2021TechnologyNew research has developed a software to more efficiently run graph applications on a wider range of computer hardware. ...Written By: Nouran AminJAN 28, 2021Earth & The EnvironmentA new prototype called RSQSim (Rate-State earthquake simulator) offers new insight into predicting massive earthquakes i ...Written By: Kathryn DeMuth SullivanJAN 07, 2021TechnologyTo combat challenges associated with increased data traffic in the ever growing digital age, researchers are developing ...Written By: Nouran AminDEC 17, 2020NeuroscienceNeuroscientists from MIT have found that reading computer code does not activate the areas in the brain used to process ...Written By: Annie LennonOCT 13, 2020MicrobiologyBacteria are everywhere, even inside of our bodies, and they are thought to date back to the early days of life on Earth ...Written By: Carmen LeitchJUL 15, 2020TechnologyResearchers have sought to develop cameras that ‘ride’ on the backs of insects, giving us an opportunity to ...Written By: Nouran AminFEB 25, 2020Drug Discovery & DevelopmentAs of February 25th 2020, there have been 80, 354 reported cases of COVID-19 (Wuhan coronavirus), including 2,707 deaths ...Written By: Annie LennonDEC 31, 2019Genetics & GenomicsComputational tools are becoming increasingly important in biological research. Now scientists have found a way to use m ...Written By: Carmen LeitchAUG 10, 2019Space & AstronomyNASA takes advantage of the Hubble Space Telescope’s powerful imaging capabilities to photograph both neighboring ...Written By: Anthony BouchardAPR 10, 2019TechnologyFacial recognition is a type of technology that analyzes the structure of the human face to determine one individual fro ...Written By: Anthony BouchardJAN 30, 2019Chemistry & PhysicsThe development of autonomous vehicles has picked up tremendous momentum in the recent decade. Armed with technologies s ...Written By: Daniel DuanDEC 17, 2018TechnologyMetamaterials have long been used by scientists for the manipulation of electromagnetic waves, like visible light, to al ...Written By: Nouran AminDEC 03, 2018NeuroscienceIdentifying the connection between the brain size to smartness has become much more plausible due to accuracy in estimat ...Written By: Aswini KannegantiJUN 26, 2018CancerAn introduction to genomics, transcriptomics, proteomics, epigenomics, and metabolomics.Written By: Mauri BrueggemanJUN 22, 2018TechnologyMIT researchers create an AI system that observes movement through partitions.Written By: Julia TraversNOV 23, 2017Chemistry & Physicsthe focus on how autonomous driving technology shapes the future of the transportation of goods. Tesla’s semi-trai ...Written By: Daniel Duan
DEC 07, 2023
Cell & Molecular Biology
Bacteria are everywhere, and so are the sticky, slimy communities they can form, called biofilms. These tough bacterial
...
Written By:
Carmen Leitch
JUN 25, 2022
Genetics & Genomics
Cephalopods, including octopuses, have exceptionally large and complex nervous systems; the octopod brain is thought to
...
Written By:
Carmen Leitch
JUN 04, 2022
Immunology
Our immune system is a crucial, and has to be ready to respond to a variety of external threats that we are constantly e
...
Written By:
Carmen Leitch
AUG 12, 2021
Clinical & Molecular DX
Researchers have developed a new technology for the non-invasive diagnosis of thyroid cancer that combines photoacoustic
...
Written By:
Tara Fernandes
AUG 05, 2021
Technology
Today, the Ethernet connection has emerged as one of the most popular ways to make the most out of an internet connectio
...
Sponsored By:
Kamil Web Solutions Lu
JUN 15, 2021
Genetics & Genomics
We live in an age of information and data, and more is being generated every day. It's estimated that there are about te
...
Written By:
Carmen Leitch
MAR 30, 2021
Cell & Molecular Biology
When cells were given a tiny 'tightrope' they 'walked' it, and researchers have discovered a new kind of cellular moveme
...
Written By:
Carmen Leitch
MAR 12, 2021
Microbiology
Many bacteria that infect intestinal cells make and release bacterial proteins into their host in order to hijack cell f
...
Written By:
Carmen Leitch
FEB 23, 2021
Technology
New research has developed a software to more efficiently run graph applications on a wider range of computer hardware.
...
Written By:
Nouran Amin
JAN 28, 2021
Earth & The Environment
A new prototype called RSQSim (Rate-State earthquake simulator) offers new insight into predicting massive earthquakes i
...
Written By:
Kathryn DeMuth Sullivan
JAN 07, 2021
Technology
To combat challenges associated with increased data traffic in the ever growing digital age, researchers are developing
...
Written By:
Nouran Amin
DEC 17, 2020
Neuroscience
Neuroscientists from MIT have found that reading computer code does not activate the areas in the brain used to process
...
Written By:
Annie Lennon
OCT 13, 2020
Microbiology
Bacteria are everywhere, even inside of our bodies, and they are thought to date back to the early days of life on Earth
...
Written By:
Carmen Leitch
JUL 15, 2020
Technology
Researchers have sought to develop cameras that ‘ride’ on the backs of insects, giving us an opportunity to
...
Written By:
Nouran Amin
FEB 25, 2020
Drug Discovery & Development
As of February 25th 2020, there have been 80, 354 reported cases of COVID-19 (Wuhan coronavirus), including 2,707 deaths
...
Written By:
Annie Lennon
DEC 31, 2019
Genetics & Genomics
Computational tools are becoming increasingly important in biological research. Now scientists have found a way to use m
...
Written By:
Carmen Leitch
AUG 10, 2019
Space & Astronomy
NASA takes advantage of the Hubble Space Telescope’s powerful imaging capabilities to photograph both neighboring
...
Written By:
Anthony Bouchard
APR 10, 2019
Technology
Facial recognition is a type of technology that analyzes the structure of the human face to determine one individual fro
...
Written By:
Anthony Bouchard
JAN 30, 2019
Chemistry & Physics
The development of autonomous vehicles has picked up tremendous momentum in the recent decade. Armed with technologies s
...
Written By:
Daniel Duan
DEC 17, 2018
Technology
Metamaterials have long been used by scientists for the manipulation of electromagnetic waves, like visible light, to al
...
Written By:
Nouran Amin
DEC 03, 2018
Neuroscience
Identifying the connection between the brain size to smartness has become much more plausible due to accuracy in estimat
...
Written By:
Aswini Kanneganti
JUN 26, 2018
Cancer
An introduction to genomics, transcriptomics, proteomics, epigenomics, and metabolomics.
Written By:
Mauri Brueggeman
JUN 22, 2018
Technology
MIT researchers create an AI system that observes movement through partitions.
Written By:
Julia Travers
NOV 23, 2017
Chemistry & Physics
the focus on how autonomous driving technology shapes the future of the transportation of goods. Tesla’s semi-trai
...
Written By:
Daniel Duan